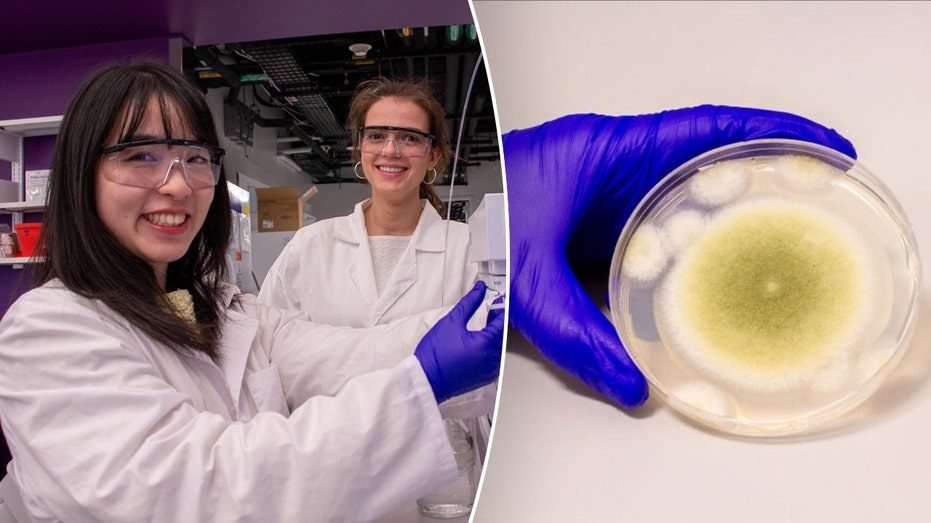

A potentially deadly fungus known as “pharaoh’s curse fungus” could offer an unexpected path to fighting cancer, recent research shows.
Scientists from the University of Pennsylvania modified molecules from the fungus — which is officially called Aspergillus flavus — to create a new compound and enhance its cancer-killing properties.
“Fungi gave us penicillin,” said Dr. Xue (Sherry) Gao, an associate professor at UPenn and leader of the study, in a press release. “These results show that many more medicines derived from natural products remain to be found.”
SINGLE DOSE OF ‘MAGIC MUSHROOMS’ PROVIDES 5 YEARS OF DEPRESSION RELIEF, RESEARCHERS FIND
The findings were published in the journal Nature Chemical Biology.
Aspergillus flavus is found in decaying leaves and compost, as well as on trees, plants and some crops, according to Mayo Clinic.
While the fungus doesn’t endanger most healthy people, it can cause respiratory issues for those who have weakened immune systems or are taking certain medications.
Some of the more severe complications of the fungus can include bleeding in the lungs and life-threatening infections in the brain, heart and kidneys, Mayo Clinic stated.
After archaeologists opened King Tut’s tomb in the 1920s, multiple members of the excavation team died suddenly, fueling rumors of a “curse” upon those who dared interfere with the pharaoh’s rest, according to the UPenn press release.
Decades later, doctors hypothesized that fungal spores, which had been dormant for thousands of years, could have infected the team.
In the 1970s, it happened again, the university stated.
A dozen scientists entered another tomb, this time in Poland — and 10 died within a few weeks. Later investigations were said to reveal the presence of Aspergillus flavus in the tomb.
Now, the same fungus linked to King Tut’s tomb could have the capability to fight leukemia in a new form of cancer therapy.
“There are a variety of compounds able to be produced by fungus,” Gao told Fox News Digital.
These compounds can be toxic to different cells, she noted, depending on the “biological management we are able to mitigate.”
CANCER COULD BE DETECTED THREE YEARS BEFORE DIAGNOSIS WITH EXPERIMENTAL BLOOD TEST
The study aimed to find a specific kind of compound — ribosomally synthesized and post-translationally modified peptides, or “RiPPs” — within Aspergillus flavus, which was previously shown to be a good source.
When this compound is able to enter cancer cells, Gao said, it may be able to stop their growth.
“Cancer cells divide uncontrollably,” Gao said in the release. “These compounds block the formation of microtubules, which are essential for cell division.”
When mixed with human cancer cells, two variants of the molecules within these RiPPS were found to have potent effects against leukemia cells, the researchers found.
Another variant performed as well as two FDA-approved drugs that have been used for decades to treat leukemia (cytarabine and daunorubicin).
Tiffany Troso-Sandoval, M.D., a medical oncologist and cancer care consultant based in New York, cautioned that this study, which was performed on cell cultures, is still in the very early stages.
YOUR FAVORITE ALCOHOLIC BEVERAGE COULD BE LINKED TO DEADLY FORM OF CANCER, STUDY FINDS
“It’s still very far away from being applicable to use in humans with leukemia,” Troso-Sandoval, who was not involved in the study, told Fox News Digital.
Speaking about RiPPs, the doctor told Fox News Digital, “What they’re referring to [in the study] is basically a rare type of bioactive molecule that they have isolated from this fungus.”
There are multiple subtypes of leukemia, Troso-Sandoval pointed out, including acute and chronic forms.
“One treatment might not work on [another] type of leukemia,” she noted. Further testing is needed to determine which subtypes may contain the active molecule.
The compound explored in the study had little to no effect on breast, liver or lung cancer cells, the researchers noted.
This suggests that its disruptive effects only work on certain types of cells, which will be an important consideration when developing medications.
CLICK HERE TO SIGN UP FOR OUR HEALTH NEWSLETTER
Looking ahead, the researchers plan to test the fungus’ potential in animal models and, ultimately, human trials.
Gao told Fox News Digital she is “excited about what nature can create and how it can benefit our society.”
For more Health articles, visit www.foxnews.com/health
The study received support from the National Institutes of Health, the University of Pennsylvania, the Welch Foundation, the Houston Area Molecular Biophysics Program, the Cancer Prevention and Research Institute of Texas and the National Science Foundation.
Latest & Breaking News on Fox News